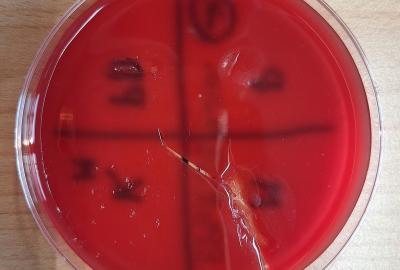
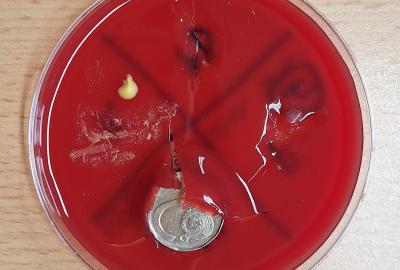
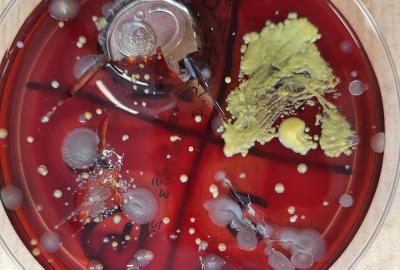
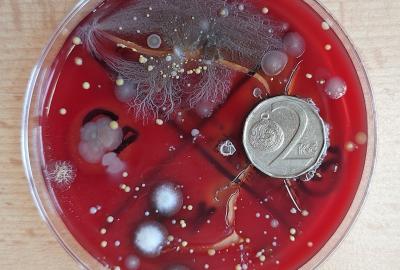
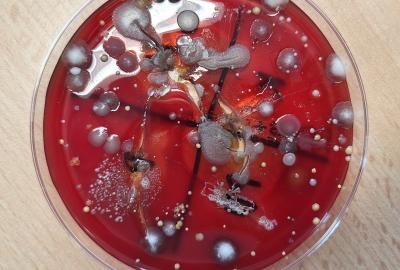

Badatelská výuka
Badatelsky orientovaná výuka je skvělá příležitost, jak vést výuku zábavně, smysluplně a efektivně. Přináší nadšení do hodin, podporuje zvídavost žáků a zároveň rozvíjí klíčové kompetence potřebné pro život. Při bádání žáci zkoumají problémy, kladou otázky, plánují a provádí pokusy, formulují závěry a prezentují výsledky. My jsme získali podnět ke zkoumání od maminky Elišky, která nám poskytla potřebné pomůcky. Povídali jsme o našem zdraví. Žáci se zamýšleli nad otázkou, co způsobuje nemoci a jak je možné jim předcházet. Informace získali na jednotlivých stanovištích, kde je měli zaznamenané na mluvítku. Vše si zapisovali do pracovního listu. Jedním ze způsobů, jak předcházet nemocem, je posilovat svou imunitu. Řekli jsme si, co pro posílení imunity děláme. Někdy ovšem ani to nestačí a my onemocníme. Nemoci mohou způsobovat viry či bakterie. Jsou to mikroorganismy, které běžným okem nevidíme. My jsme se rozhodli si některé z těchto mikroorganismů "vypěstovat" a dokázat tak, že skutečně existují. Pracovali jsme ve skupinách. Každá skupina si připravila misku s krevním agarem. Misku jsme rozdělili na 4 díly a postupně jsme nanášeli - stěr kliky frekventovaných dveří, otisk prstu, otisk prstu natřeného desinfekcí a otisk mince. Někteří minci ponechali vloženou v agaru. Misky jsme zavřeli, popsali a nyní necháme inkubovat při pokojové teplotě 3 - 7 dní. Teď už jen čekáme, jaké kolonie nám v miskách narostou - bakterie, plísně nebo kvasinky. Zajímavé bylo, že jedna z misek byla již kontaminovaná a už zde rostla bakteriální kolonie. Čtvrtý den jsme mohli pozorovat narůstající kolonie. Žáci si svá pozorování zakreslili do pracovních listů. Věřím, že ruce už si budou mýt opravdu pečlivě :-).